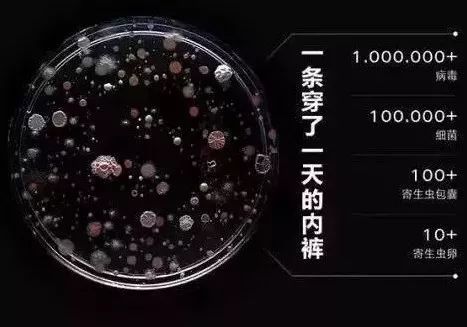

央视曝光:内裤天天洗,竟还有100万个细菌?80%女性已经中招!
2019年11月23日

女人一生完孩子
毁了两样东西:肚子和子宫

就连胯骨也变宽,买鞋子都

严重时,整个屋子都是这味

负离子磁疗技术,排毒养宫
预防妇科病










抹平腹部赘肉,矫正盆骨变形
重回少女身材












面料丝滑舒服,一点不勒肉






好评不断,回购无限!






![]() 或戳下方「阅读原文」进入购买专区
或戳下方「阅读原文」进入购买专区
7阅读
0赞
是收到货款11
